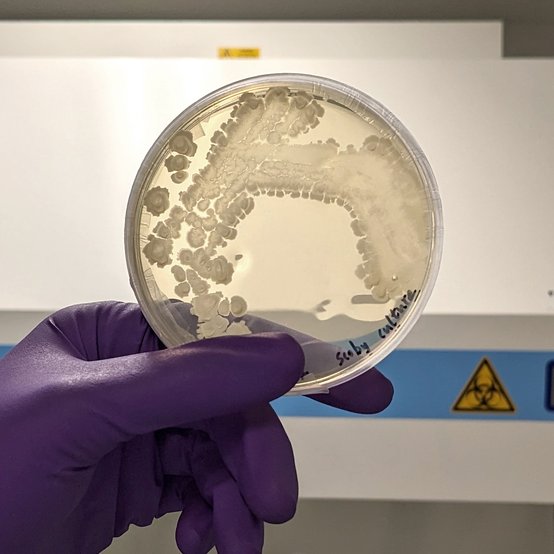

Overview
Go beyond boundaries to create impact
Key details
- 360 credits
- 2 year programme
- Full-time study
School or Centre
Current location
- Battersea
Next open event
- 3 Jun 2026
- Visit Open Studio Event
Next application deadline
- 3 Jun 2026
- Still accepting applications
Career opportunities
- IDE graduates head into diverse creative careers as consultants, innovators, entrepreneurs, researchers, freelancers or within corporations.
A programme for fiercely curious changemakers
- Benefit from our powerful partnership with Imperial College London and our extensive alumni network
- Learn from academics making an impact in everything from biomaterials to AI
- Sharpen the skills you need to be an innovator – whether you want to be an industry leader, entrepreneur or researcher
IDE is about transformation. Transformation of the practices that transcend disciplinary boundaries. Transformation of the understanding of how the past, present and future can identify opportunities to create lasting impact. Transformation of you as an individual into a creative leader.
Run jointly with Imperial College London for 40 years, this unique double Master’s programme in Innovative Design Engineering (IDE) will help you integrate design and engineering with science and enterprise. Past RCA IDE students have looked at everything from medical devices that manage health conditions to systems for protecting the environment against pollution.
Experience the power of collaboration
Transdisciplinary teamwork is at the core of our approach, encouraging collaboration with industry and a wide range of stakeholders. IDE nurtures a supportive, empathic culture – the IDE family – both during your studies and through our extensive alumni network.
We aim to create a new type of innovator capable of tackling the complex challenges faced by society and the planet. By the time you graduate, you’ll not only have the necessary technical skills but also be fiercely curious, open-minded, empathic, and analytical.
Follow in the footsteps of students and alumni who have won national and international awards, including the National James Dyson Award, which our students have won three years in a row. Notpla, co-founded by IDE students, won the Earthshot prize for creating a solution to the global plastic packaging problem.
Explore further and apply now
Catch the replays from our latest online Open Day.
Watch portfolio advice from the programme team.
Applications are now open for September 2026 entry. Round 3 application deadline: 3 June 2026, 12 noon (UK time). Apply now.
Student and alumni stories
Gallery
Staff
Facilities
The School of Design is based across our Battersea and Kensington sites.
View all facilitiesStudents have access to the College’s workshops, with traditional facilities for woodworking, metalworking, plastics and resins, including bookable bench spaces. Computer-driven subtractive milling equipment is available, as well as additive rapid prototyping.
Our alumni
Our alumni form an international network of creative individuals who have shaped and continue to shape the world. Click on each name to find out more.
Where will the RCA take you?More details on what you'll study.
Find out what you'll cover in this programme.
What you'll cover
Programme stucture
The two-year IDE programme consists of three phases, each characterising the overall nature of the content and learning at each phase. Phase 1: Foundations (Terms 1 & 2) is concerned with students gaining confidence and exploring the IDE transdisciplinary landscape and toolbox building. Phase 2: Consolidation (Terms 3 & 4) is during the summer and the transition period with students working independently, developing their individual and professional agency. Phase 3: Mastery (Terms 5 & 6) is the final period for students to develop significant agency in their own areas of interest and emerging professional pathways, creating a substantial springboard into next steps for ventures, research and careers – and lasting impact.
Phase 1: Terms 1 & 2
Phase 1 is made up of a series of units: IDE Fundamentals; Transdisciplinary Practices; Cyber Physical Systems; Regenerative Materials; Structures & Aesthetics; and Impact.
Each of these units focuses on a particular aspect of innovation, design and engineering and involves practice, as well as research activities within the development of products, services, systems, campaigns and experiences, and in exploring broader societal challenges.
In each unit, you will undertake a design-led project to a brief - sometimes set and sometimes of your own devising. Emphasis is placed on generating imaginative ideas, development and validation through testing prototypes, simulation and gaining feedback from expert stakeholders such as potential end users, designers, engineers and entrepreneurs
Phase 2: Terms 3 & 4
Phase 2 comprises two units, Sustainable Systems and Agency & Implementation, and is about professional consolidation. During phase 2 you will develop your individual and professional agency, identity and pathways through engagement with organisations, your own ventures or within research fields. Phase 2 culminates in you defining and planning your team and individual projects for Phase 3.
Phase 3: Terms 5 & 6
Phase 3 includes a series of units to strengthen your professional agency, leadership, knowledge and skills. Phase 3 includes a team-based project, individual projects and an elective module. The elective modules enable you to develop specialisms in particular areas of interest to you. The thematic areas you choose to explore in your team and individual projects can be diverse and are supported by a broad range of expert tutors.
Requirements
What you need to know before you apply
The programme accepts a wide range of applicants – we want diversity of expertise, culture and experience and we welcome applicants from fields such as business, social science, and the arts in addition to engineering, science and design. Candidates who can demonstrate outstanding potential to develop creative, technical and innovation qualities.
Generally, we are looking for pioneering applicants to demonstrate their:
- creativity, imagination and innovation;
- ability to clearly display and articulate the intentions of your work;
- intellectual engagement in areas relevant to the work and subjects that matter to you;
- technical skills appropriate to IDE and rigour in your approach;
- potential to direct and navigate their learning journey within the structure of the programme, and achieve MA and MSc standards overall.
IDE is a double Master's programme run jointly between the RCA and Imperial College London, and consequently, applicants need to meet the requirements of both institutions. Candidates for IDE are normally required to have at least a UK honours degree at 2:1 level (or the equivalent) in any subject relevant to innovation. It is desirable for candidates to have some relevant work experience.
In exceptional circumstances applicants without the required degree qualification will be considered, for example, excellent professional experience or outstanding creative or technical abilities. Special cases for admissions require unanimous approval from the IDE Entrance Examination Board, then approval by the RCA’s Academic Board for Concessions and Discipline (ABCD) and Imperial’s Programme’s Committee.
What's needed from you
Portfolio requirements
Upload a single PDF format (maximum 20 pages) compilation of work from your previous studies, professional work and personal interests. This should aim to show:
- the excellence of your current expertise, study area or professional activity
- evidence of your interests and ability in the fields of innovation, design and/or engineering
- samples of your creative abilities.
The portfolio content could include: projects and exercises from previous degree courses where relevant, examples of professional work; personal sketchbooks or working sketches; self-generated projects; evidence of an ability to make in 3D; as well as examples of creative work in any other areas.
Each piece of work or project should include clear information about the nature of the work and your role in it, for example, if it is individual work, group work, commercial work in a team, etc.
Personal statement
Please provide a 300-word written personal statement that addresses the following points:
- Introduce yourself, your interests and your motivations for applying to the Royal College of Art, and to this programme in particular.
- Briefly summarise any educational background and professional experience to date that will support your application.
- Tell us what you want to do in the future.
Video requirements
We ask that you upload a two-minute video recorded on your phone or laptop, speaking to us directly.
High production qualities are not needed. We will review the work in your portfolio, so keep your video simple. We are interested in what you say to find out about you, your thinking, background and ambitions. Respond to a minimum of three of the following prompts. Consider these as the types of questions you would be asked in a face-to-face interview.
- Who or what inspires you?
- How do you hope to incorporate this inspiration into your work?
- What are your aspirations for your future professional life and how will IDE help you get there?
- Talk about what unique skills or perspectives you will bring to the IDE student group.
English-language requirements
If you are not a national of a majority English-speaking country you will need the equivalent of an IELTS Academic score of 6.5 overall (with a minimum of 5.5 in every component)
You are exempt from this requirement if you have received a 2.1 degree or above from a university in a majority English-speaking nation within the last five years.
If you need a Student Visa to study at the RCA, you will also need to meet the Home Office’s minimum requirements for entry clearance.
Fees & funding
For this programme
Fees for new students
Fees for September 2026 entry on this programme are outlined below. Students starting their second year from September 2026 will pay the same fees outlined below for the new first year students. From 2021 onward, EU students are classified as Overseas for tuition fee purposes.
Home
Overseas and EU
Please note
*Fees for Year 2 of this programme are agreed between Imperial College London and RCA, and will be published on the RCA website at the latest 3 months before commencement of Year 2. Total cost is based on the assumption that the programme is completed in the timeframe stated in the programme details. Additional study time may incur additional charges.
Deposit
New entrants to the College will be required to pay a non-refundable deposit in order to secure their place. This will be offset against the tuition fees.
Home
Overseas and EU
Progression discount
For alumni and students who have completed an RCA Graduate Diploma and progress onto an RCA MA programme, a progression discount of £1,000 is available.
Scholarships
Scholarships
Each year, the RCA scholarship programme supports hundreds of students. The following scholarships are confirmed for this programme, with additional awards added throughout the year.
House of Fraser Bursary
Eligible programmes: Architecture MA Architecture (ARB/RIBA Part 2), Interior Design MA, City Design MA, Environmental Architecture MA, Ceramics & Glass MA, Contemporary Art Practice MA, Curating Contemporary Art MA, V&A/RCA History of Design MA, Jewellery & Metal MA, Painting MA, Photography MA, Print MA, Sculpture MA, Writing MA, Animation MA, Digital Direction MA, Information Experience Design MA, Visual Communication MA, Design Products MA, Fashion MA, Innovation Design Engineering MA/MSc, Intelligent Mobility MA, Service Design MA, Textiles MA
Other criteria: None
Eligible fee status: Home fee status
Value: £10,000 toward fees
James Dyson Foundation Bursary
Eligible programmes: Innovation Design Engineering MA/MSc
Other criteria: None
Eligible fee status: Home fee status
Value: £10,000 toward fees per year
Pokémon Scholarship
Eligible programmes: Architecture MA Architecture (ARB/RIBA Part 2), Ceramics & Glass MA, Jewellery & Metal MA, Sculpture MA, Digital Direction MA, Information Experience Design MA, Visual Communication MA, Design Products MA, Fashion MA, Innovation Design Engineering MA/MSc, Intelligent Mobility MA, Textiles MA
Other criteria: None
Eligible fee status: Home or overseas status
Value: If Home: Full Tuition Fee & Maintenance. If Overseas: Tuition Fee Discount
RCA President & Vice-Chancellor’s International
Round 1 and 2 programme applications will be automatically assessed for one of these scholarships. If you are successful, you will be told about this at the same time as receiving your RCA programme offer.
Eligible programmes: Architecture MA Architecture (ARB/RIBA Part 2), Interior Design MA, City Design MA, Environmental Architecture MA, Ceramics & Glass MA, Contemporary Art Practice MA, Curating Contemporary Art MA, V&A/RCA History of Design MA, Jewellery & Metal MA, Painting MA, Photography MA, Print MA, Sculpture MA, Writing MA, Animation MA, Digital Direction MA, Information Experience Design MA, Visual Communication MA, Design Products MA, Fashion MA, Innovation Design Engineering MA/MSc, Intelligent Mobility MA, Service Design MA, Textiles MA, Creative Education MEd, Communication MFA, Master of Research RCA MRes, Design Futures MDes, Arts & Humanities MFA, Design Practice MArch
Other criteria: Applicants from Australia, Brazil, Canada, Chile, Colombia, Denmark, Egypt, France, Germany, Greece, Hong Kong, India, Indonesia, Israel, Italy, Japan, Malaysia, Mexico, Netherlands, Nigeria, Pakistan, Palestine, Poland, Portugal, Saudi Arabia, Singapore, South Korea, Spain, Switzerland, Taiwan, Thailand, Turkey, UAE, USA
Eligible fee status: Overseas fee status
Value: £9,000 toward fees
RCA President & Vice-Chancellor’s UK Scholarship
Round 1 and 2 programme applications will be automatically assessed for one of these scholarships. If you are successful, you will be told about this at the same time as receiving your RCA programme offer.
Eligible programmes: Architecture MA Architecture (ARB/RIBA Part 2), Interior Design MA, City Design MA, Environmental Architecture MA, Ceramics & Glass MA, Contemporary Art Practice MA, Curating Contemporary Art MA, V&A/RCA History of Design MA, Jewellery & Metal MA, Painting MA, Photography MA, Print MA, Sculpture MA, Writing MA, Animation MA, Digital Direction MA, Information Experience Design MA, Visual Communication MA, Design Products MA, Fashion MA, Innovation Design Engineering MA/MSc, Intelligent Mobility MA, Service Design MA, Textiles MA, Creative Education MEd, Communication MFA, Master of Research RCA MRes, Design Futures MDes, Arts & Humanities MFA, Design Practice MArch
Other criteria: None
Eligible fee status: Home fee status
Value: £5,000 toward fees
The RCA UK Disabled Students’ Scholarship
For students who identify as D/deaf or disabled
Eligible programmes: Architecture MA Architecture (ARB/RIBA Part 2), Interior Design MA, City Design MA, Environmental Architecture MA, Ceramics & Glass MA, Contemporary Art Practice MA, Curating Contemporary Art MA, V&A/RCA History of Design MA, Jewellery & Metal MA, Painting MA, Photography MA, Print MA, Sculpture MA, Writing MA, Animation MA, Digital Direction MA, Information Experience Design MA, Visual Communication MA, Design Products MA, Fashion MA, Innovation Design Engineering MA/MSc, Intelligent Mobility MA, Service Design MA, Textiles MA, Creative Education MEd, Communication MFA, Master of Research RCA MRes, Design Futures MDes, Arts & Humanities MFA, Design Practice MArch
Other criteria: None
Eligible fee status: Home fee status
Value: £6,000 towards living costs
The Sir Frank Bowling Scholarship
For students identifying as Black or Black British - Caribbean, Black or Black British - African, Other Black background, Mixed - White and Black Caribbean, Mixed - White and Black African
Eligible programmes: Architecture MA Architecture (ARB/RIBA Part 2), Interior Design MA, City Design MA, Environmental Architecture MA, Ceramics & Glass MA, Contemporary Art Practice MA, Curating Contemporary Art MA, V&A/RCA History of Design MA, Jewellery & Metal MA, Painting MA, Photography MA, Print MA, Sculpture MA, Writing MA, Animation MA, Digital Direction MA, Information Experience Design MA, Visual Communication MA, Design Products MA, Fashion MA, Innovation Design Engineering MA/MSc, Intelligent Mobility MA, Service Design MA, Textiles MA, Creative Education MEd, Communication MFA, Master of Research RCA MRes, Design Futures MDes, Arts & Humanities MFA, Design Practice MArch
Other criteria: None
Eligible fee status: Home fee status
Value: Full fees and maintenance
Even if you do not currently see a scholarship for which you meet the eligibility criteria, we encourage you to apply to be considered for financial support.
Unless otherwise stated, you must apply in either round 1 or 2, and have received an offer of study on an RCA programme to be invited to make a scholarship application. Therefore, we strongly recommend you apply for your programme as early as possible but no later than the round 2 deadline.
More information
Additional fees
In addition to your programme fees, please be aware that you may incur other additional costs associated with your study during your time at RCA. Additional costs can include purchases and services (without limitation): costs related to the purchase of books, paints, textiles, wood, metal, plastics and/or other materials in connection with your programme, services related to the use of printing and photocopying, lasercutting, 3D printing and CNC. Costs related to attending compulsory field trips, joining student and sport societies, and your Convocation (graduation) ceremony.
If you wish to find out more about what type of additional costs you may incur while studying on your programme, please contact the Head of your Programme to discuss or ask at an online or in person Open Day.
We provide the RCASHOP online, and at our Kensington and Battersea Campuses – this is open to students and staff of the Royal College of Art only to provide paid for materials to support your studies.
We also provide support to our students who require financial assistance whilst studying, including a dedicated Materials Fund.
External funding
There are many funding sources, with some students securing scholarships and others saving money from working. It is impossible to list all the potential funding sources; however, the following information could be useful.
Payments
Tuition fees are due on the first day of the academic year and students are sent an invoice prior to beginning their studies. Payments can be made in advance, on registration or in two instalments.
MA/MSc fees
Students on this programme pay the tuition fees direct to the RCA.
In addition to the tuition fee, students will need to cover other non-academic costs such as flights, visas, accommodation, insurance and general living expenses.
Experience
The social media content shown here reflects past and current student activity and is provided for illustrative purposes only. Experiences on the programme may vary and are subject to change for future students.
Start your application

Change your life and be here in 2026. Applications now open.
The Royal College of Art welcomes applicants from all over the world.
Before you begin
Make sure you've read and understood the application process and deadlines.
Application key datesCheck you the programme-specific entrance and portfolio requirements on the programme page.
Consider attending an Open Event, either online or in person, or watch recordings of previous events.
See upcoming events and recordingsPlease note, all applications must be submitted by 12 noon on the given deadline.
Ask a question
Get in touch if you’d like to find out more or have any questions.
[email protected]